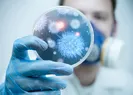
Dünyayı şoke eden sonuç! Kanalizasyonda çıktı

ABD basını koronavirüse karşı verilen mücadelede Hz. Muhammed'i örnek gösterdi ve “Temizlik” vurgusu yaptı
Coronavirüse karşı ilk başta sıkı tedbirler almayarak salgının yayılmasına yol açan ABD’de durum her geçen gün kötüye gidiyor. Ölü sayısının bini geçtiği ABD’de coronavirüs vakası ise 69 binin üzerinde yer alıyor. ABD’nin haftalık haber dergisi Newsweek, salgın hastalıklar ile ilgili Peygamber Efendimiz Hz. Muhammed'i örnek gösterdi ve “Temizlik” vurgusu yaptı.
Nesweek, koronavirüs salgını ile mücadelede Peygamber efendimiz Hz. Muhammed'i örnek gösterdi. Haberde, bazı uzmanların salgına karşı temizlik uyarıları aktarılırken, "Bir salgın sırasında başka kimin hijyen ve karantina önerdiğini biliyor musunuz? 1300 yıl önce İslam Peygamberi Hz. Muhammed." ifadeleri kullanıldı.
HZ. MUHAMMED ÖRNEĞİ
Haberde, bazı uzmanların salgına karşı temizlik uyarılarına yer verilirken "Bir salgın sırasında başka kimin hijyen ve karantina önerdiğini biliyor musunuz? 1300 yıl önce İslam Peygamberi Hz. Muhammed." ifadeleri kullanıldı.

KARANTİNA TAVSİYESİ
Hz. Muhammed'in, koronavirüs gibi ölümcül hastalıkları önlemek ve bu gibi salgınlarla mücadele etme konusunda sağlıklı tavsiyelerde bulunduğu belirtildi. İslam Peygamberi'nin, salgın hastalık riskine karşı, ashabına yaptığı bir tavsiyede karantina uygulamasına dikkat çektiği ifade edildi.
TEMİZLİK VURGUSU
Ayrıca Hz. Muhammed'in, insanları enfeksiyondan koruyacak hijyenik uygulamalara uymaya da teşvik ettiği de hatırlatılarak, "Temizlik, imanın yarısıdır. Uyandıktan sonra ellerinizi yıkayın; uyurken ellerinizin nereye hareket ettiğini bilmiyorsunuz. Yemekten önce ve sonra ellerinizi yıkayınız." tavsiyeleri de aktarıldı.